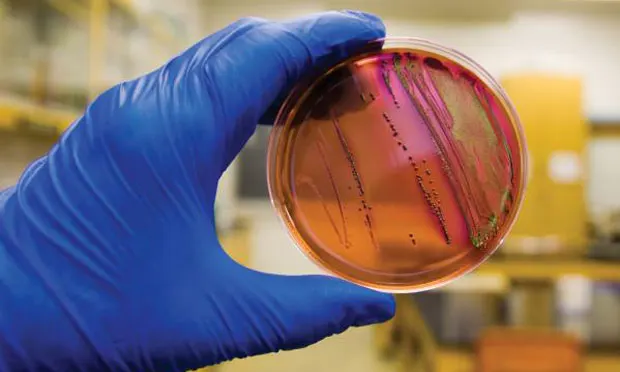

PROFILE
Definition
A urinary tract infection (UTI) occurs when a bacterium, such as uropathogenic Escherichia coli, overcomes host defenses and adheres to, multiplies, and persists in the urinary tract.
Simple UTI
These infections involve the bladder and are typically initial infections with no concurrent disease or underlying structural or functional abnormality (ie, no compromise of host defense mechanisms).
Complicated UTI
These infections are associated with pyelonephritis, prostatitis, concurrent systemic diseases (diabetes mellitus, hyper-adrenocorticism), and either systemic (corticosteroid use) or local (indwelling urinary catheter, uroliths, neoplasia) alterations in immunity through compromised host defense mechanisms.
Related Article: Surgeon's Corner: Vulvoplasty
Incidence/Prevalence
E coli is the most common bacterium isolated in canine and feline UTIs.1,2
Approximately 14% of dogs have UTI during their lifetime, but young, healthy cats have an innate resistance and rarely develop UTI.3
Signalment
Age
Dogs may have UTI at any age.
Cats older than 10 years of age are predisposed and usually have concurrent illness.
Sex
Female dogs are at increased risk for UTI due to easier ascension of bacteria through a shorter urethra. In male dogs, UTI is generally classified as complicated.
Causes
E coli, a gram-negative bacterium, has been isolated in 44% of all canine UTIs and in as many as 67% of feline UTIs.1,4 Other bacteria associated with UTI include Staphylococcus, Streptococcus, Enterococcus, Proteus, and Klebsiella species.
Risk Factors
UTI is associated with alterations in the host’s systemic or local immunity, such as immunosuppression, diabetes, hyperadrenocorticism, anatomic abnormalities (polyps/tumors, recessed vulva), indwelling catheters, uroliths, or urethral sphincter mechanism incompetence.
In cats, risk factors include diabetes mellitus, hyperthyroidism, and renal disease.<sup2 sup>
Pathophysiology
E coli is considered a normal component of gastrointestinal and distal urogenital flora, but it can ascend the urethra and gain entrance to the urinary tract. Hematogenous spread is uncommon.
Specific virulence factors found in E coli allow it to adhere to and invade host cells, produce toxins, utilize host nutrients, and evade the host’s immune system.
Signs
History
Thorough medical history, including details of previous UTI, current or recent medications, and response to treatment, is essential.
Patient history for UTI typically includes changes in urination (amount, frequency, color, straining). Pollakiuria, stranguria, hematuria, and malodorous urine may indicate cystitis. Dogs with pyelonephritis or prostatitis may have polyuria/polydipsia and signs of systemic illness, such as lethargy, anorexia, and vomiting.
Some dogs have silent UTIs with no urinary signs, although they may have evidence or history of concurrent disease.
Physical Examination
Findings on physical examination may be normal in simple UTI.
Thorough examination for complicated UTI should include abdominal palpation for hepatomegaly, renal pain, thickened bladder wall, and cystouroliths; rectal palpation for prostatomegaly, urethral uroliths, and thickened urethra; and external examination for recessed vulva (Figure 1).
Figure 1. A 1-year-old golden retriever with recessed vulva and evidence of skinfold pyoderma is prepared for episioplasty. Photo courtesy of Emily Klocke, DVM, Diplomate ACVS

DIAGNOSIS
Definitive
Urine culture and susceptibility testing, preferably on a sample obtained by cystocentesis or urinary catheter, are definitive for UTI. Other methods of collection require a quantitative culture to rule out contamination.
Differential
While infection with E coli is most common, many bacteria, including Staphylococcus, Streptococcus, Enterococcus, Proteus, and Klebsiella species, may be responsible. Fungal organisms can also cause UTI.
Laboratory Findings
Complete blood count will be within the reference intervals and is not required for diagnosis of simple UTI. However, an increase in white blood cells may be present with pyelonephritis or prostatitis.
Serum biochemical profile will show abnormalities consistent with the underlying disease (chronic kidney disease, hyperadrenocorticism) in complicated UTI.
Pyuria, bacteriuria (Figure 2), hematuria, or proteinuria may be noted on urinalysis.

Figure 2. Canine uirine sediment prepared as an unstained wet mount (A) and with modified Wright's stain (B) showing numerous bacilli and leukocytes (40x magnification). Courtesy of Don Peterson, DVM
Gram’s staining and measurement of urine pH may help narrow the differential diagnosis while culture is pending (Table 1). However, urine pH may be affected by other factors (fasting versus postprandial, diet, renal disease, vomiting, drugs).
Not all cases of UTI have active urine sediment; immunosuppression can block the local inflammatory response.
Minimum inhibitory concentrations (MICs) should be requested for culture and susceptibility testing of urine.
Evaluation of endocrine function is indicated if suggested by clinical presentation (measurement of serum thyroxine concentration in a cat with polyphagia, weight loss, and palpable thyroid nodule).
Imaging
For complicated UTI, radiography and ultrasonography are indicated for assessment of uroliths, pyelonephritis (Figure 3), prostatitis, adrenomegaly, or other complicating factors. Contrast studies or cystoscopy may be indicated to investigate anatomic defects.

Figure 3. Longitudinal (A) and transverse (B) renal ultrasound images of an 8-year-old female domestic shorthaired cat with pyelonephritis. These images show dilation of the renal pelvis, which is characteristic of pyelonephritis.
TREATMENT
Simple versus complicated infections, location of infection, susceptibility of strain, adverse effects of antimicrobial agents, and client compliance issues should be evaluated prior to treatment for E coli infections.
Most patients are treated as outpatients, but patients with pyelonephritis or prostatitis due to infection with E coli may benefit from hospitalization and supportive care.
Most infections can be effectively managed or cured with appropriate antimicrobial treatment, but episioplasty may be indicated in female dogs with a recessed vulva. Surgery or lithotripsy for uroliths or surgical resection of polyps/tumors should be performed when possible.
Concurrent conditions should be identified and managed appropriately to minimize risk for UTI recurrence.
Antimicrobials
Complete 10- to 14-day course for simple UTI or 4 to 6 weeks for complicated UTI.
Empirical antimicrobial selection can be based on urinalysis findings for simple UTI. Most E coli strains are susceptible to amoxicillin, amoxicillin–clavulanic acid, or cephalexin. Enrofloxacin should be avoided as first-line treatment because of resistance.5
Antimicrobial choice for complicated UTI should be based on culture and susceptibility testing and the ability of the drug to achieve more than 4 times the reported MIC in urine.
A lipid-soluble antimicrobial agent that can cross the blood–prostate barrier, such as enrofloxacin, chloramphenicol, or trimethoprim–sulfamethoxazole, is recommended for prostatitis. Castration should be performed after acute inflammation resolves.
Supportive Treatment
Some supportive treatments prescribed in conjunction with appropriate antimicrobial treatment and monitoring (Table 2) may be suitable for patients with recurrent E coli UTI.
Note**:** Further research is required to determine efficacy, safety, and optimal dosing profiles for these treatments in companion animals.
Methenamine is a urinary antiseptic that is converted to formaldehyde and can have bactericidal activity against E coli.6 Methenamine is often administered with a urinary acidifier; however it is contraindicated in dogs with metabolic acidosis (chronic kidney disease, diabetic ketoacidosis) and is not well tolerated by cats.
Proanthocyanidins (found in cranberries) can prevent E coli adhesion to the uroepithelium.7 Preliminary research suggests cranberry extract has antiadhesive effects in canine urine.8,9
D-mannose is a sugar that competitively binds to mannose-sensitive fimbriae on E coli, which can inhibit adhesion to or displace adhered E coli from the uroepi-thelium.<sup10 sup>
Forskolin is the main active ingredient in the Asiatic herb Coleus forskohlii and may stimulate exocytosis of E coli from the urinary bladder wall.11 It may be useful in relapsed UTI with suspected poor antimicrobial penetration.

FOLLOW-UP
Patient Monitoring
Optimal monitoring for complicated and recurrent UTI includes urine culture 3 to 5 days after initiation of treatment.
No growth on culture suggests effective treatment.
Growth on culture suggests ineffective treatment, and antimicrobial choice should be reconsidered.
Bacterial culture should be negative prior to discontinuation of treatment and again 5 to 7 days following discontinuation of antimicrobial treatment.
Recurrence and Resistance
Recurrence of UTI with the same organism warrants further investigation of potential problems with antimicrobial treatment and/or reevaluation for a source of the infection (uroliths or neoplasia).
Recurrence of UTI with a different organism warrants further investigation for a cause of immunosuppression.
Preventive low-dose antimicrobial treatment (eg, nitrofurantoin 4 mg/kg PO once at bedtime instead of Q 8 H) may be indicated for recurrent E coli UTI with an identifiable underlying cause. Low-dose treatment should be initiated after the current infection is properly controlled (following 4–6 weeks of antimicrobial treatment at the therapeutic dose and a negative urine culture).
IN GENERAL
Relative Cost
Simple UTI
The cost for a physical exam, urinalysis, +/- urine culture & susceptibility, and cost of antimicrobial treatment: $-$$
Complicated UTI
The total expense for initial extensive diagnostic testing, antimicrobial treatment, and multiple follow-up cultures can be costly: $$$-$$$$

UTI = urinary tract infection